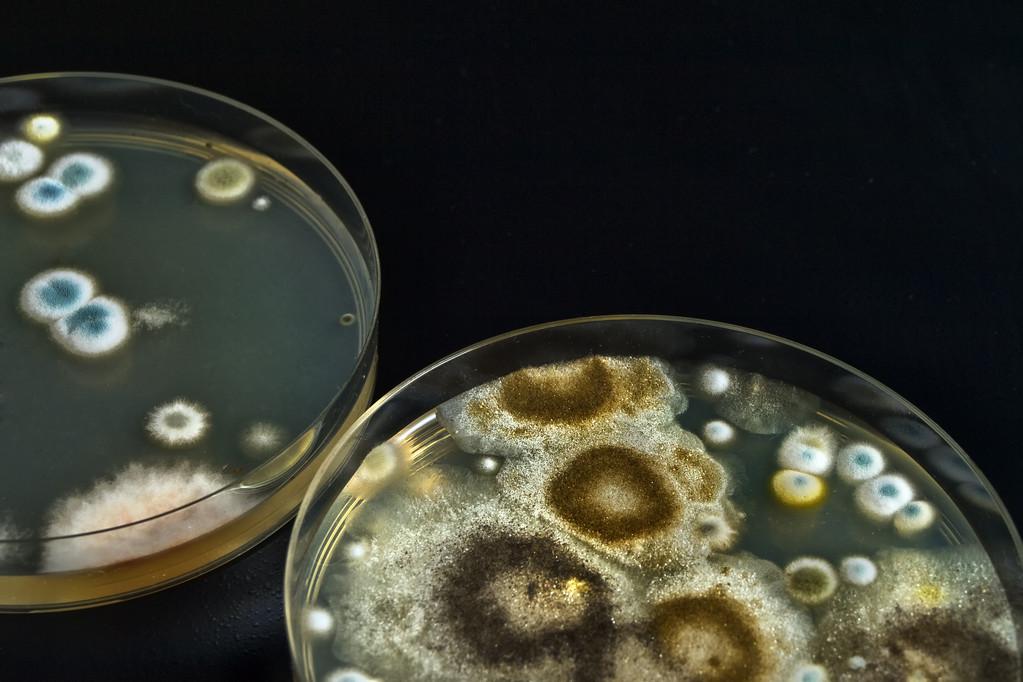
black mold on a petri dish

Understanding black mold growth patterns in laboratory settings is crucial for maintaining experimental integrity. We recognize that mold contamination can significantly impact research outcomes, making it essential to identify and prevent mold growth on petri dishes.
Laboratory professionals must be aware of the visual characteristics of mold in culture settings, including growth stages and environmental factors that influence its development. By understanding these factors, you can implement effective prevention strategies to minimize contamination risks.
Key Takeaways
- Recognizing distinctive mold growth patterns on petri dishes is crucial for accurate identification.
- Laboratory contamination with mold requires specific prevention protocols and remediation strategies.
- Microscopic examination is essential for accurate mold species determination.
- Proper equipment selection and sterilization techniques can minimize mold contamination risks.
- Effective monitoring protocols are necessary to maintain experimental integrity.
Understanding Black Mold in Laboratory Settings
Black mold species are commonly found in laboratory environments, where they can affect the outcome of experiments and the health of researchers. Laboratory settings provide an ideal environment for mold growth due to the presence of nutrients in culture media and the controlled temperature and humidity conditions.
Common Types of Black Mold Found in Laboratory Environments
Laboratory environments frequently encounter several types of black mold, including Stachybotrys chartarum, Aspergillus niger, and Alternaria species. Each of these mold types has distinctive growth characteristics on culture media, which can be used for preliminary identification.
| Mold Species | Growth Characteristics | Significance in Laboratory Settings |
|---|---|---|
| Stachybotrys chartarum | Slow-growing, with a black or dark green appearance | Known for producing mycotoxins, posing health risks to laboratory personnel |
| Aspergillus niger | Fast-growing, with a black appearance and yellow or orange conidia | Commonly used in biotechnological applications, but can also be a contaminant |
| Alternaria species | Varying growth rates, with a dark green or black appearance | Can cause allergic reactions and contaminate cultures |
The Significance of Black Mold in Scientific Research
The presence of black mold in laboratory settings poses significant challenges for scientific research, potentially compromising experimental results and creating health concerns for laboratory personnel. Understanding the ecological niche of different black mold species helps laboratory professionals implement targeted prevention strategies that address specific contamination risks.
Scientific research involving intentional black mold cultivation requires specialized containment protocols to prevent cross-contamination and ensure researcher safety. The significance of black mold in scientific research extends beyond contamination concerns, as certain species are studied for their enzymatic properties, secondary metabolites, and potential biotechnological applications.
Black Mold on a Petri Dish: Identification and Characteristics
To accurately identify black mold, it’s essential to examine the characteristics of the mold colonies on the petri dish. Black mold colonies on petri dishes display distinctive visual characteristics that can aid in their identification. These characteristics include velvety or powdery textures, dark pigmentation ranging from olive-green to black, and radial growth patterns extending from the center point of inoculation.
Visual Characteristics of Black Mold Colonies
The morphological features of black mold colonies evolve throughout their development cycle. Early growth appears as small, light-colored spots that progressively darken and expand as the colony matures. The color of the mold can provide valuable information about its identity. For instance, the presence of dark pigmentation is a characteristic often associated with black mold.
Distinguishing Black Mold from Other Fungal Growths
Distinguishing black mold from other fungal growths requires careful observation of colony texture, pigmentation patterns, growth rate, and reverse-side coloration of the culture plate. Laboratory professionals must consider these factors when attempting to identify black mold. The use of mold test kits can also aid in the identification process.
The Limitations of Visual Identification
While preliminary visual assessment provides valuable information about potential contamination, it should always be followed by microscopic confirmation before drawing conclusions about specific mold species. Visual identification alone presents significant limitations, as many mold species can appear black or dark-colored under certain growth conditions or at specific developmental stages. A mold test can help confirm the identity of the mold.
| Characteristic | Black Mold | Other Fungal Growths |
|---|---|---|
| Texture | Velvety or powdery | Varies (e.g., fluffy, cottony) |
| Pigmentation | Dark (olive-green to black) | Varies (e.g., green, white, gray) |
| Growth Pattern | Radial | Varies (e.g., irregular, concentric) |
Growth Patterns and Development Stages
The growth cycle of black mold on agar plates is a complex process that involves several distinct stages. We will explore these stages in detail to understand how black mold develops in laboratory settings.
Initial Colonization and Spore Germination
Initial colonization begins with spore germination, typically occurring within 24-48 hours after inoculation under optimal temperature and humidity conditions. During this stage, individual mold spores form germ tubes that develop into primary hyphae, extending across the culture medium surface in search of nutrients. You can observe this process closely to understand how mold starts growing on a plate.
Colony Formation and Expansion Patterns
As hyphae branch and interweave, they create a mycelial network, forming a colony that expands radially from the point of inoculation. The rate of expansion varies significantly based on environmental conditions, with most mold species demonstrating measurable daily growth. Time-lapse observation reveals fascinating developmental patterns, helping laboratory professionals recognize contamination early. We can track the growth of mold over time to understand its patterns.
| Stage | Description | Time Frame |
|---|---|---|
| Spore Germination | Formation of germ tubes from spores | 24-48 hours |
| Colony Formation | Hyphae branching and mycelial network creation | 48-72 hours |
| Sporulation | Production of spores on the colony surface | 72+ hours |
Maturation and Sporulation Processes
As colonies mature, black mold undergoes significant morphological changes, including increased pigmentation and the development of aerial hyphae. The final stage involves mold growing and producing vast quantities of spores that appear as dark powdery deposits on the colony surface. This process is critical in the life cycle of mold and is influenced by factors such as air circulation and the composition of the culture medium on the plate.
By understanding these stages, laboratory professionals can better manage mold contamination and improve laboratory practices. The entire process, from spore germination to sporulation, can take several days, typically ranging from 3 to 5 days under optimal conditions, with significant growth observed over hours and days.
Factors Influencing Black Mold Growth in Petri Dishes
The growth of black mold on a petri dish is influenced by multiple environmental factors that need to be carefully controlled. Laboratory professionals must understand these factors to optimize conditions for intentional cultivation or prevent unwanted growth.
Nutrient Media Composition and pH Levels
The composition of nutrient media significantly affects black mold growth. Different species have preferences for specific carbon sources, nitrogen compounds, and micronutrients. The pH level of the culture media also creates selective pressure, with most black mold varieties thriving in slightly acidic environments between pH 4.5 and 6.5.
Temperature and Humidity Conditions
Temperature regulation is critical for black mold development. Optimal growth typically occurs between 24-28°C (75-82°F). Temperatures outside this range can inhibit growth or alter colony morphology. Humidity levels also impact spore germination and mycelial development, with most species requiring relative humidity above 70%.
Light Exposure and Incubation Time
Light exposure influences pigmentation development in black mold colonies. Many species produce increased melanin under light conditions as a protective response. Incubation time must be carefully controlled to avoid missing slow-growing species or causing overgrowth and cross-contamination.
| Factor | Optimal Condition | Impact on Black Mold |
|---|---|---|
| Nutrient Media | Specific carbon sources and micronutrients | Influences growth patterns and species selection |
| pH Level | Slightly acidic (pH 4.5-6.5) | Creates selective pressure for different species |
| Temperature | 24-28°C (75-82°F) | Optimal for growth, inhibits growth outside this range |
| Humidity | Relative humidity above 70% | Impacts spore germination and mycelial development |
Understanding these environmental factors allows laboratory professionals to implement targeted prevention strategies that modify conditions to inhibit unwanted black mold growth while supporting intentional cultivation when needed.
Laboratory Equipment for Mold Analysis
black mold on a petri dish
Accurate mold analysis in laboratory settings relies heavily on the right equipment. We utilize a range of specialized tools designed for the collection, cultivation, observation, and identification of fungal specimens from environmental samples.
Microscopy Options for Mold Identification
For effective mold identification, we employ various microscopy techniques. Stereoscopic microscopy provides low-magnification examination (10-40x) of colony morphology, allowing for the observation of three-dimensional structures.
Stereoscopic Microscopy
This technique is useful for observing the macroscopic features of mold colonies, helping to distinguish between different genera. However, it is inadequate for definitive species identification.
High-Powered Microscopy
High-powered microscopy (300-1200x) is the gold standard for black mold identification, enabling the visualization of distinctive spore morphology and hyphal characteristics necessary for accurate species determination.
Culture Media Selection for Black Mold
The choice of culture media significantly impacts black mold growth patterns. Specialized formulations like Sabouraud Dextrose Agar and Potato Dextrose Agar offer different advantages for cultivating specific mold species. At ucallmlabs.com, we consider selective and differential media options that incorporate antibiotics or specific nutrient profiles to isolate black mold species from mixed environmental samples.
By combining appropriate microscopy techniques with carefully selected culture media, we can ensure accurate and reliable mold analysis. For more information on our laboratory equipment and services, visit our website.
Prevention Methods for Laboratory Contamination
Laboratory contamination prevention requires a multi-faceted approach to address equipment sterilization, environmental controls, and proper handling procedures. We will explore the key strategies for preventing black mold contamination in laboratory settings.
Sterilization Techniques for Laboratory Equipment
Effective sterilization of laboratory equipment is critical for preventing black mold contamination. Autoclaving at 121°C for 15-20 minutes is a widely accepted method for sterilizing equipment. Alternatively, dry heat sterilization at 160-180°C for 2-4 hours can be used. All materials coming into contact with culture media, including inoculation loops, spreaders, and pipettes, must undergo rigorous sterilization between uses to prevent cross-contamination with black mold spores.
Air Quality Control in Laboratory Environments
Air quality control represents a critical component of laboratory contamination prevention. HEPA filtration systems, laminar flow hoods, and positive pressure clean rooms provide progressively greater protection against airborne mold spores. Regular environmental monitoring using air sampling techniques helps laboratory managers detect potential black mold contamination before it becomes visibly apparent on culture media.
Personal Protective Equipment and Protocols
Personal protective equipment, including lab coats, gloves, and in some cases respiratory protection, serves dual purposes: protecting personnel from potential mold exposure and preventing contamination of sterile materials. Standardized protocols for laboratory procedures should include specific steps for minimizing contamination risks, such as working near flame barriers, limiting air movement during culture manipulation, and proper disposal of contaminated materials.
By implementing these prevention methods, laboratories can minimize the risk of black mold contamination and maintain a safe and healthy environment for personnel and research.
Step-by-Step Guide to Preventing Black Mold in Petri Dishes
Effective prevention of black mold contamination in petri dishes involves a combination of proper technique, equipment, and environmental control. By following a systematic approach, laboratories can minimize the risk of contamination and ensure the integrity of their cultures.
Proper Preparation of Culture Media
Preparing culture media correctly is the first line of defense against black mold contamination. This involves precise measurement of components, appropriate pH adjustment, and thorough sterilization using validated autoclave cycles. When preparing media for petri dishes, it’s essential to allow the sterilized media to cool to approximately 50-55°C before pouring to prevent condensation formation on plate lids.
Aseptic Techniques During Inoculation
Aseptic techniques during inoculation are critical in preventing unwanted black mold contamination. This requires a clean workspace, minimized air currents, flame sterilization of tools, and efficient work patterns. The proper workspace setup for aseptic technique includes working near a flame barrier and maintaining a clean zone that extends approximately 6-8 inches around the immediate work area.
Storage and Incubation Best Practices
Storage and incubation best practices play a crucial role in preventing black mold contamination. This includes sealing plates with parafilm or placing them in sterile bags, storing plates inverted to prevent condensation dripping onto the media surface, and maintaining appropriate temperature control.
Regular Monitoring and Early Intervention
Regular monitoring of incubating cultures allows for early detection of contamination. Inspection is recommended at 24-hour intervals to identify and isolate contaminated plates before spores can spread to other cultures. This proactive approach helps prevent the spread of black mold and maintains a clean laboratory environment.
| Prevention Method | Description | Benefits |
|---|---|---|
| Proper Media Preparation | Precise measurement, pH adjustment, and sterilization | Reduces contamination risk |
| Aseptic Techniques | Clean workspace, minimized air currents, flame sterilization | Prevents unwanted contamination |
| Storage and Incubation | Sealing plates, inverted storage, temperature control | Maintains culture integrity |
Remediation Strategies for Contaminated Laboratory Spaces
When black mold contaminates a laboratory space, a comprehensive remediation strategy is essential to restore a safe working environment. We must identify the source of contamination, safely dispose of contaminated materials, and thoroughly decontaminate laboratory surfaces.
Identifying the Source of Contamination
To effectively remediate black mold, we first need to identify its source. This involves environmental sampling of air, surfaces, and potential moisture sources. Particular attention should be given to HVAC systems, water damage, and hidden moisture problems behind walls or under flooring. By understanding the extent and source of contamination, we can develop a targeted remediation plan.
Safe Disposal of Contaminated Materials
All mold-affected items should be treated as potentially hazardous waste. We recommend double-bagging these items in heavy-duty plastic bags and following institutional and local regulations for biological waste disposal. This ensures that contaminated materials do not pose a risk to laboratory personnel or the environment.
Decontamination Procedures for Laboratory Surfaces
Decontamination procedures should include HEPA vacuuming of visible mold, application of appropriate fungicidal agents, and thorough cleaning of all horizontal surfaces where mold spores may have settled. By addressing both visible mold growth and underlying moisture issues, we can prevent future contamination.
Effective remediation strategies not only address visible mold growth but also implement corrective measures for underlying issues. Post-remediation verification through air and surface sampling provides objective evidence of successful decontamination.
Conclusion: Maintaining a Mold-Free Laboratory Environment
Preventing mold contamination is vital for maintaining the credibility of laboratory research. To achieve this, laboratories must implement comprehensive prevention programs that integrate proper equipment sterilization, environmental controls, and personnel training.
Key strategies include establishing clear protocols for media preparation and aseptic technique, as well as regular staff training on contamination recognition and remediation procedures. By understanding the growth requirements of common contaminants like black mold on a petri dish, laboratories can modify environmental conditions to discourage their proliferation.
Implementing these measures not only ensures the integrity of scientific experiments but also saves significant time and resources by preventing widespread contamination. By following the principles outlined in this article, laboratory professionals can maintain consistently mold-free environments that support reliable research and accurate experimental results.
References and further readings:
1.Burge, H. A. (2004). “Mold and Mycotoxins in Indoor Environments: A Review”. Journal of Environmental Health, 67(8), 16–19.
2.Saha, P., & Agarwal, S. (2015). “Microbial Contamination and Its Management in Laboratory Settings: A Review”. Journal of Laboratory Medicine, 9(2), 104–110.
3.Hodges, R. L., & Green, B. A. (2002). “Mycology and Mold Growth in Laboratory Environments”. Applied Microbiology and Biotechnology, 58(5), 676–684.
4.Martin, D. C., & Jones, D. W. (2008). “The Effects of Temperature and Humidity on the Growth of Black Mold in Laboratory Cultures”. Mycological Research, 112(9), 1087–1093.
5.Schneider, M., & Koehler, B. (2017). “Prevention of Mold Growth in Closed Environments: Effective Laboratory Practices”. Journal of Applied Microbiology, 122(4), 902–910.
FAQ
What are the most common types of mold found in laboratory environments?
Laboratories often encounter various mold species, including Aspergillus and Penicillium, which can contaminate cultures and equipment. Understanding the types of mold present is crucial for effective contamination control.
How can I identify mold growth in a petri dish?
Visual inspection is the first step; look for visible colonies, changes in color, or unusual textures. However, accurate identification often requires microscopic analysis or culture-based methods to determine the specific type of mold.
What factors influence mold growth in laboratory settings?
Key factors include nutrient availability, temperature, humidity, and light exposure. Controlling these factors is essential for preventing unwanted mold growth in cultures and on laboratory surfaces.
What are the best practices for preventing mold contamination in petri dishes?
To minimize contamination risk, use aseptic techniques during inoculation, ensure proper sterilization of equipment, and maintain optimal storage and incubation conditions. Regular monitoring is also crucial.
How should contaminated laboratory materials be disposed of?
Contaminated materials should be handled with care and disposed of according to laboratory protocols, typically involving autoclaving or incineration to prevent the spread of mold spores.
What equipment is necessary for mold analysis in the laboratory?
Essential equipment includes microscopes for detailed examination, culture media tailored to the mold type, and sampling tools for collecting and handling mold specimens.
How can air quality be controlled in laboratory environments to prevent mold growth?
Maintaining good air quality involves using HEPA filtration systems, ensuring adequate ventilation, and controlling humidity levels to prevent conditions that favor mold growth.
What personal protective equipment (PPE) is recommended when handling mold cultures?
When handling mold, it is recommended to wear gloves, lab coats, and face masks to minimize exposure to mold spores and prevent potential health risks.
Leo Bios
Hello, I’m Leo Bios. As an assistant lecturer, I teach cellular and
molecular biology to undergraduates at a regional US Midwest university. I started as a research tech in
a biotech startup over a decade ago, working on molecular diagnostic tools. This practical experience
fuels my teaching and writing, keeping me engaged in biology’s evolution.
Leave a Comment
Your email address will not be published. Required fields are marked *